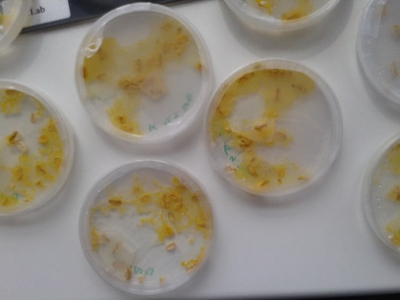

CoolMint, Paderborn (NRW)
Die Resonanz bei Schulen und Unternehmen rund um das zdi-Schülerlabor coolMINT.paderborn war so groß, dass in Paderborn gleich 15 Schülerteams an den Start gehen. Mehr als 60 Schülerinnen und Schüler bearbeiten die Projekte von insgesamt sieben Firmen: sie bringen ihre innovativen Ideen ein und lernen dabei gleichzeitig unternehmerisches Handeln kennen. Dabei reicht das Themenspektrum von der Lichttechnik „Intelligentes Licht in der Stadt“ über den Maschinenbau „Anreißvorrichtung für die Bearbeitung einer Mischtrommel“ bis zur Informatik „Entwickeln eines auf Geodaten basierenden Informationstools“.
Durch die große Resonanz wurde die Kick-Off-Veranstaltung auf zwei Termine aufgeteilt. Am Donnerstag, den 17. September 2015 trafen im Heinz Nixdorf MuseumsForum 13 Schülerinnen und Schüler des St.-Ursula Gymnasiums Neheim auf Vertreter des Lichtforums NWR. Schulleiter Bertin Kotthoff fasst zusammen: „Unglaublich, wie engagiert die Schülerinnen und Schüler bei der Sache sind.“ 16 Jugendliche vom beruflichen Gymnasium Ingenieurwissenschaften des Richard-von-Weizsäcker Berufskollegs, Paderborn, stimmten die Zielsetzung ihrer Projekte mit Michael Grimme von Loedige Maschinenbautechnik ab. Dieser staunte: „Die Schülerinnen und Schüler sprudeln nur so von Ideen.“
Der zweite Teil des Kick-Off-Treffens fand am Freitagvormittag, 18.September 2015, im Richard-von-Weizsäcker Berufskollegs statt. Dort steckten 33 Schülerinnen und Schüler des beruflichen Gymnasiums Informatik mit den auftraggebenden Firmen INCONY AG, Connext Communications GmbH, wabsolute GmbH, Wincor Nixdorf AG und ORDIX AG die Projektziele ab und besprachen das weitere Vorgehen. Brigitte Hoop, Leiterin des beruflichen Gymnasiums: „Junge Menschen benötigen eine klare Perspektive, um bestmögliche Entwicklungschancen wahrzunehmen. Der Übergang in das Berufsleben stellt für viele eine große Hürde dar. Mit Lab2Venture ist uns ein wichtiger Schritt in diese Richtung gelungen: Im beruflichen Gymnasium für Ingenieurwissenschaften und Informatik führt die hochtechnologische Ausbildung zukünftig nicht nur zur Allgemeinen Hochschulreife, sondern bestenfalls auch gleich zu einem Vertrag mit einem Dualen Partner für eine qualifizierende Ausbildung oder ein Studium. Eine Win-Win-Situation für unsere Region.“
DLR_School_Lab TU Dresden (Sachsen)
Lesen Sie hier in Kürze Neuigkeiten von der Projektarbeit des DLR_School_Lab TU Dresden
Grünes Labor Gatersleben (Sachsen-Anhalt)
Neuigkeiten von der Projektarbeit des Grünes Labors Gatersleben
Das Grüne Labor Gatersleben ist ein Schülerlabor auf dem Biotech Campus des Leibniz Instituts für Pflanzengenetik und Kulturpflanzenforschung (IPK) und möchte in erster Linie Schüler für die Natur und Naturwissenschaften insbesondere Biologie und Biotechnologie interessieren. Damit möchte unser gemeinnütziger Verein zur Umweltbildung beitragen und Nachwuchskräfte für die MINT Berufe gewinnen. Durch die große Nachfrage können wir jährlich mehr als 5000 Kursteilnehmer, vor allem Schüler und Schülerinnen aus den benachbarten Landkreisen, begrüßen. Das Lab2Venture Projekt ist für uns eine neue Herausforderung, weil wir bisher nicht direkt mit den Firmen unserer Region, abgesehen vom IPK, in Projekten zusammengearbeitet haben. Die Idee Aufträge von Firmen von engagierten Schülern im Schülerlabor als unternehmerische Projekte gemäß der TheoPrax Methode zu erfüllen, ergänzt in idealerweise unser Angebot. Für das Lab2Venture Projekt konnten wir 2 Firmen und Schüler von 2 Gymnasien bereits gewinnen. Die erste Projektgruppe des Stephaneums aus Aschersleben steht bereits in den Startlöchern und wird für die Firma "TraitGenetics GmbH" eine neue effektive und schnelle DNA Isolierungsmethode für schwierige pflanzliche Gewebe erarbeiten. Damit ist ein sehr gutes Thema gefunden worden, da das Schülerlabor über die technische Ausstattung für molekularbiologisches Arbeiten verfügt.
Jugendforschungszentrum Schwarzwald-Schönbuch e.V. (Baden-Württemberg)
Liebe Jugendliche,
Wie programmiere ich einen Roboter? Wie schnell verläuft eine chemische Reaktion? Wie arbeitet ein 3D-Drucker? Und? Und? Und?
Habt ihr Lust, solchen Fragen nachzugehen? Dann seid ihr hier genau richtig! Im Jugendforschungszentrum gibt es viele interessante Geräte, mit denen ihr nach Herzenslust tüfteln, experimentieren und forschen könnt. Eure angefangenen Experimente dürft ihr hier stehen lassen und immer daran weiterforschen, wann ihr Zeit habt. Das JFZ macht es euch möglich, durch „learning by doing“ ohne Prüfungsangst und Notenstress eure Begeisterung für Naturwissenschaft und Technik zu entdecken.
Wie finde ich ein cooles Projekt?
- Ich habe schon eine Idee und bringe diese mit
- Ich erkundige mich im JFZ, welche Projekte gerade trendy sind
- Ich überlege mir zusammen mit dem JFZ, was ich machen könnte
Als Anregung hier einige abgeschlossene Projekte:
- Wie kann man aus Plastikabfällen Dieselkraftstoff herstellen?
- Wie kann ein Waschmaschinensensor selbständig erkennen, ob genügend Waschmittel in der Lauge ist?
- Wie steuert man einen Multicopter mit GPS?
- Antibiotika in mediteranen Pflanzen
.jpg)
Wie funktioniert das JFZ?
Von Dienstag bis Samstag Nachmittag stehen für euch die Türen des JFZ offen. Kommt einfach vorbei, schaut euch an wie man in lockerer Atmosphäre zusammen mit anderen Jugendlichen interessanten Fragestellen auf den Grund gehen kann.
Im JFZ stehen euch 15 Betreuer zur Verfügung, die euch beraten und euch beim Experimentieren weiterhelfen. Unsere Betreuer sind Studierende von Hochschulen und Universitäten sowie erfahrene Naturwissenschaftler und Ingenieure aus der Praxis.
Wir laden euch ein, mitzumachen! Meldet euch per Email an oder kommt einfach vorbei.
Wie kann man ein eigenes Projekt auf Wettbewerben vorstellen und Preise gewinnen?
Wenn man mit einem Projekt fast fertig ist, meldet man es zum Beispiel beim Wettbewerb Schüler experimentieren oder Jugend forscht an und reicht eine schriftliche Ausarbeitung über die Forschungsergebnisse ein. Jedes Jahr haben Schüler des JFZ Regionalsiege eingeheimst und Plätze auf dem Siegertreppchen eingenommen.
Was kostet das JFZ?
Alle anfallenden Kosten werden über Sponsorengelder von Firmen und Institutionen gefördert. Das Forschen ist für euch kostenlos. Natürlich freuen wir uns über eine Mitgliedschaft eurer Eltern im Förderverein (der Jahresbeitrag beträgt nur 25 € ) ist aber nicht Bedingung.
Seid ihr neugierig geworden und habt Interesse?
Dann kommt einfach vorbei oder informiert euch weiter unter: www.jugendforschungszentrum.de oder
Adresse: Vogelsangweg 3, 72202 Nagold
Öffnungszeiten: Dienstag – samstags von 13.00 – 18.00 Uhr
http://SWR 3 Landesmobil im JFZ
Wir danken allen die das Jugendforschungszentrum unterstützen und fördern!
MINT Campus Dachau (Bayern)
Lesen Sie hier in Kürze Neuigkeiten von der Projektarbeit des MINT Campus Dachau
NatLab (Berlin)
Kurzbeschreibung


Das Schülerlabor NatLab der Freien Universität Berlin war eines von zehn Laboren, das an der ersten Ausschreibung von „Lab2Venture“ teilgenommen und positive Erfahrungen damit gemacht hat, dass Schüler_innen reale naturwissenschaftliche Aufträge selbstständig bearbeiten. Die Schüler_innen haben bestätigt, Wichtiges für die Zukunft gelernt zu haben, wie z.B. Teamarbeit und langfristige Projektplanung. Auch der Einblick in unternehmerisches Denken und Handeln war für sie wichtig.
In der ersten Förderperiode hat das NatLab zwei Auftragsrunden mit zwei verschiedenen Modellen ausprobiert. In der ersten Runde wurden befreundete Schulen eingeladen daran teilzunehmen, in der zweiten Runde besonders interessierte Schüler_innen. Die erste Runde hat gezeigt, wie wichtig es ist, dass die beteiligten Lehrkräfte nicht nur an den naturwissenschaftlichen Aspekten der Aufträge interessiert sein müssen, sondern auch an den wirtschaftlichen. In der zweiten Runde wurde deutlich, wie schwer es für interessierte Schüler_innnen ist, den Auftrag zu erfüllen, wenn die Unterstützung der Schule fehlt. Auch ist eine verstärke Koordination wichtig, wenn sich Schüler_innnen von mehreren Schulen schulübergreifend an einem so einem komplexen Projekt wie bei Lab2Venture mitarbeiten.
Jetzt beteiligt sich das NatLab mit elf weiteren Schülerlaboren aus ganz Deutschland an „Lab2Venture plus“, das wie die erste Ausschreibung vom Bundesministerium für Wirtschaft und Energie gefördert wird. Sehr positiv hat sich die frühzeitige Einbindung der Lehrkräfte und studentischen Betreuer_innen der Schülerlabore bemerkbar gemacht. Sowohl am Auftaktworkshop am 06.12.2014 am Bundesministerium für Wirtschaft und Energie, der gemeinsam vom TheoPrax-Zentrum des Fraunhofer ICT, der Deutschen Kinder- und Jugendstiftung (DKJS) und LernortLabor - Bundesverband der Schülerlabore e.V. durchgeführt wurde, als auch beim Qualifizierungs-Workshop im Juli 2015 waren die Lehrkräfte und Labormitarbeiter_innen beteiligt. Die betreuenden Studierenden waren beim Qualifizierungs-Workshop beteiligt, was sie gut auf die Arbeit mit den Schüler_innen vorbereitet hat.
Nach den beiden Kick-Off-Veranstaltungen (6.10. und 21.12.2015), bei denen die Teilnehmer_innen zusammen mit den Auftraggeber_innen den Auftrag schärften, fanden auftragsspezifische Workshops statt. Die Schüler_innen konnten diese aus einem Potpourri von möglichen Workshops aussuchen und so zusätzliche Qualifikationen erwerben, die entweder für die Gruppe oder den Auftrag wichtig waren, wie z.B. Workshops zu „Kreativitätstechniken“ oder „Projektmanagement“.
Die Endpräsentation der Ergebnisse findet gemeinsam mit dem Schülerforschungszentrum Berlin am 18. Juli 2016 im Kongress-Zentrum des Bundesministeriums für Wirtschaft und Energie statt.
Veröffentlichungen zum Thema (chronologisch):
- van der Kooi, K.: Gute Ideen verwirklichen. in campus.leben (2014) → Link
- Wein, M.: Vom Menthol-Versuch zur Geschäftsidee. in Schülerlabor-Atlas 2015 (2015) → Link
- Middeldorf, A.: Unternimm mal was!. in campus.leben (2015) → Link
Projektthemen/Aufträge – Lab2Venture plus

Auftrag 1: Graphische Gestaltung des 3. Experimentierhandbuches des Forschergartens
Das Gläserne Labor ist ein Schülerlabor auf dem Biotech-Campus Buch. Der Forschergarten, eine Ausgründung des Gläsernen Labors, bietet Experimente zu vielen Themen aus der alltäglichen Erlebniswelt für Kinder in Kita und Grundschule an. Um Erzieher_innen und Lehrer_innen die Möglichkeit zu geben, ausgewählte Experimente selbst vor Ort durchzuführen, wurden in den vergangenen Jahren bereits zwei Bücher mit Anleitungen für Experimente zusammengestellt. Diese Sammlungen haben zum Ziel, Betreuer_innen und Lehre_innen erprobte Experimentieranleitungen an die Hand zu geben und sie zum Durchführen einfacher Experimente gemeinsam mit den Kindern zu ermutigen.
Im Rahmen dieses Auftrags sollen die Schüler_innen eine weitere Experimentesammlung des Gläsernen Labors druckreif machen. Die Experimente sollen von den Schüler_innen durchgeführt und fotografisch dokumentiert werden. Die Texte des Skripts müssen gelayoutet und zum Drucken vorbereitet werden.
| Auftraggeberin: | Claudia Jacob (Gläsernes Labor) |
| Auftragnehmer_innen: |
4 Schüler_innen des Werner-von-Siemens-Gymnasiums Berlin |
| Stud. Betreuer: | Jakob Schweer |
| Lehrer: |
Andreas Hoffmann (Werner-von-Siemens-Gymnasium Berlin) |
Auftrag 2: Reduzierung der Lebensmittelverschwendung in den Lebensbereichen Haushalt und Schule
„Verluste und Verschwendung von Nahrungsmitteln bereiten weltweit und somit auch in Deutschland große Probleme, denen zu begegnen eine besondere Herausforderung darstellt. Die wissenschaftliche Literatur sowie öffentliche und politische Debatten haben sich dieser Thematik in den letzten Jahren verstärkt gewidmet (FAO 2013: Food Wastage Footprint: Impacts on Natural Resources). [...] Die Studie „Tonnen für die Tonne“ (WWF Deutschland, 2012) hat gezeigt, dass in Deutschland insbesondere die Lebensmittelverschwendung auf der Haushaltsebene ein bedeutender Faktor ist, der sich nicht nur ungünstig auf die Nahrungsmittelverfügbarkeit, sondern auch negativ auf die Umwelt auswirkt.“ (Quelle: „Das große Wegschmeißen“, WWF Deutschland, 2015)
Im Rahmen dieses Auftrages sollen die Schüler_innen innovative Konzepte entwickeln, welche der Lebensmittelverschwendung in den Lebensbereichen Haushalt und Schule entgegenwirken und/oder ihre Mitmenschen für dieses Thema sensibilisieren sollen.
| Auftraggeberin: | Birgit Eichmann (WWF Deutschland) |
| Auftragnehmer_innen: |
6 Schülerinnen des Rheingau-Gymnasiums Berlin 45 Schüler_innen des Arndt-Gymnasiums Berlin |
| Stud. Betreuer: | René Mückai |
| Lehrer_innen: |
Alexander Denzin (Rheingau-Gymnasium Berlin) Simona Bleeck (Arndt-Gymnasium Berlin) Susanne Heubach (Arndt-Gymnasium Berlin) Susann Lange (Arndt-Gymnasium Berlin) |
Auftrag 3: Erfassung des Wissenstands in Bezug auf die Lebensmittelsicherheit bei Produkten tierischer Herkunft
Lebensmittelinfektionen und Vergiftungen sind auf eine Vielzahl bakterieller, viraler und parasitärer Krankheitserreger zurückzuführen. Oftmals sind die Krankheit‐Symptome beim Menschen schwach und harmlos, können aber auch lebensbedrohlich werden. Infektionen mit einem bakteriellen Erreger über kontaminierte Lebensmittel fanden im Verlauf eines Jahres zu 35,9% in Privathaushalten statt, in der Schule oder im Kindergarten zu 4,2% (Schmidt, K.: UGB‐Forum 5/00, S. 230‐233).
Im Rahmen dieses Auftrages sollen die Schüler_innen mittels einer Umfrage mit einem selbstständig entworfenen Fragebogen den Wissensstand bei jungen Erwachsenen zum Thema Infektionsrisiko durch Lebensmittel erheben. Zusätzlich soll durch eine Dokumentation von kritischen Punkten, wo eine eventuelle Kontamination des Lebensmittels mit bakteriellen Erregern oder eine ungenügende Reduktion von Erregern erfolgen könnte, beim eigenen Herstellungsprozess von Mozzarella durchgeführt werden.
| Auftraggeber: | Prof. Dr. Marcus Doherr (Institut für Veterinär-Epidemiologie und Biometrie, FU Berlin) |
| Auftragnehmer_innen: | 4 Schüler_innen des Thomas-Mann-Gymnasiums Berlin |
| Stud. Betreuerin: | Carina Zernke |
| Lehrer: | Birk Richter (Thomas-Mann-Gymnasium Berlin) |
Chronologie – Lab2Venture plus


| 06.12.2014 |
Auftaktworkshop / Lehrerforum im Bundesministerium für Wirtschaft und Energie (gemeinsam |
| 24.+25.06.2015 |
Qualifizierungs-Workshop an der Freien Universität Berlin |
| 06.10.2015 |
Kick-Off-Veranstaltung 1 in den Räumen des Veterinarium Progressum der FU Berlin Workshop „Projektmanagement“ (durchgeführt von TheoPrax) |
| 21.12.2015 |
Kick-Off-Veranstaltung 2 in der Aula des Arndt-Gymnasiums in Berlin-Dahlem Workshop „Projektmanagement“ (durchgeführt von TheoPrax) Workshop „Kreativitätstechniken“ (durchgeführt von DKJS) |
| 26.02.2016 | Workshop „Kreativitätstechniken“ in den Räumen des Rheingau-Gymnasiums (durchgeführt von DKJS) |
| 04.03.2016 | Workshop „Layout und Design“ in den Räumen des NatLab (durchgeführt von DKJS) |
| 18.07.2016 | Abschlussveranstaltung mit Präsentation der Ergebnisse im Kongress-Zentrum des Bundesministeriums für Wirtschaft und Energie (zusammen mit dem Schülerforschungszentrum Berlin) |
Projektthemen/Aufträge – Lab2Venture

Auftrag 1: Optimierung der Kultivierungsbedingungen des Schleimpilzes Physarum polycephalum
Der Schleimpilz Physarum polycephalum bietet sich als anschaulicher Modellorganismus für den Biologieunterricht an, da seine Kultur unter einfachen Bedingungen möglich ist und einfache Zellen bereits auf sichtbare Größe heranwachsen.
Im Rahmen dieses Auftrags sollten die Schüler_innen die Kultivierung des Schleimpilzes erforschen und den Einfluss unterschiedlicher Faktoren, wie etwa Gravitation, Temperatur, Lichteinfall und Nährmedium auf das Wachstum untersuchen.
| Auftraggeber: | Stephan Schmidt (Carolina Science GmbH) |
| Auftragnehmer_innen: |
16 Schüler_innen der Bertolt-Brecht-Oberschule Berlin 9 Schüler des Werner-von-Siemens-Gymnasiums Berlin |
| Stud. Betreuer: |
Ansgar Thode Julius Frotscher |
| Lehrer_innen: |
Rainer Hüttner (Bertolt-Brecht-Oberschule Berlin) Karen Flesch (Werner-von-Siemens-Gymnasium Berlin) |
Auftrag 2: Erstellung eines Imagefilmes für das Schülerlabor-Netzwerk GenaU
Im Netzwerk GenaU sind 15 Berliner und Brandenburger Schülerlabore an Forschungseinrichtungen oder Hochschulen zusammengeschlossen.
Im Rahmen dieses Auftrages sollten die Schüler_innen einen Imagefilm erstellen, welcher über die dem Netzwerk zugehörigen Schülerlabore informiert und diese bewirbt. Hierzu sollten Filmarbeiten im Schülerlabor mit einer besuchenden Schulklasse durchgeführt, die besuchenden Schüler_innen befragt und das erhaltene Filmmaterial geschnitten werden.
| Auftraggeberin: | Christina Seidler (Netzwerk GenaU) |
| Auftragnehmer_innen: | 3 Schüler_innen der John-F.-Kennedy-Schule Berlin |
| Stud. Betreuer: |
Ansgar Thode Julius Frotscher |
Auftrag 3: Untersuchung des Einflusses physikalischer Parameter auf die Umkristallisation von Methanol
Im pharmakologischen Bereich ist die genaue räumliche Anordnung der Atome in einem Molekül von großer Bedeutung. So können Moleküle, die sich zueinander wie Bild und Spiegelbild verhalten, sogenannte Enantiomere, im Körper stark unterschiedliche Reaktionen hervorrufen. Im Extremfall mag ein Enantiomer als Medikament fungieren, während das andere giftig ist. Daher ist die saubere Aufarbeitung und Trennung von Enantiomeren von großer Wichtigkeit, jedoch aufgrund ihrer Ähnlichkeit oft nicht einfach.
Im Rahmen dieses Auftrages sollten die Schüler_innen im Labor den Einfluss verschiedener physikalischer Faktoren, wie Temperatur und Bewegung der Lösung, auf die Umkristallisation der Enantiomere des Menthols in verschiedenen Lösungsmitteln untersuchen.
| Auftraggeberin: | Sonja Jost (DexLeChem Berlin Engineering) |
| Auftragnehmer_innen: | 5 Schüler_innen verschiedenen Schulen |
| Stud. Betreuer: | Julius Frotscher |
Auftrag 4: Erstellung eines Vorbereitungskonzeptes für Schüler mit Lernschwierigkeiten für den Kurs
„Wir analysieren Honig“
„Die Heinrich-Zille-Grundschule liegt mitten in Berlin-Kreuzberg. Genau wie in Kreuzberg gibt es an unserer Schule viele verschiedene Menschen: große und kleine, dicke und dünne, alte und junge, schnelle und langsame, arme und reiche, Menschen mit und ohne Behinderungen, Menschen mit und ohne Sorgen! Unsere Schule ist so bunt, lebendig und vielfältig wie der Bezirk um uns herum. Wir wollen eine Schule für alle Kinder sein!“ (Quelle: Heinrich-Zille-Grundschule, http://www.heinrich-zille-grundschule.de)
Im Rahmen dieses Auftrages sollten die Schüler_innen vorbereitende Unterrichtsmaterialien für einen Besuch des NatLab-Kurses „Wir analysieren Honig“ entwerfen. Dabei galt es gründliche Recherche über die Erfordernisse der Inklusionsschüler_innen einer 5. Klasse durchzuführen und bereits vorhandene Kursmaterialien und Begleitumstände des Kurses zielgruppenorientiert anzupassen.
| Auftraggeber: | Claus Brencher (Heinrich-Zille-Grundschule Berlin) |
| Auftragnehmer_innen: | 3 Schüler_innen der Anna-Freud-Schule |
| Stud. Betreuerin: | Clara von Randow |
Chronologie – Lab2Venture

| 13.02.2013 |
Kick-Off-Veranstaltung des ersten Durchlaufs in den Räumen des Institutes für Workshop „Projektmanagement“ (durchgeführt von TheoPrax) |
| 05.06.2013 | Abschlussveranstaltung des ersten Durchlaufs mit Präsentation der Ergebnisse in den Räumen des Institutes für Anorganische Chemie der FU Berlin |
| 02.09.2013 |
Kick-Off-Veranstaltung des zweiten Durchlaufs in den Räumen des Institutes für Workshop „Projektmanagement“ (durchgeführt von TheoPrax) |
| 18.-20.10.2013 | Ideenlabor am Werbellinsee (gemeinsam durchgeführt von DKJS und TheoPrax) |
| 14.12.2013 | Workshop „Kommunikation“ in den Räumen des NatLab (durchgeführt von DKJS) |
| März 2014 | Workshops "Präsentationstechniken" (durchgeführt von Profund Innovation) |
| 26.03.2014 | Abschlussveranstaltung des zweiten Durchlaufs mit Präsentation der Ergebnisse in den Räumen des Institutes für Anorganische Chemie der FU Berlin |
OJW-Karlsruhe (Baden-Württemberg)
Hohenwettersbacher Str. 36
76228 Karlsruhe-Grünwettersbach
L2V-Zwischenbericht Januar 2016
1. Vorlauf:
Nach dem Auftakt-Workshop Lab2Venture (L2V) am 5./6. Dezember 2014 in Berlin, war das Frühjahr 2015 geprägt durch intensive Suche nach Schulpartnern und Firmen für das Lab2Venture Projekt mit der Offenen Jugendwerkstatt Karlsruhe (OJW). Fast 20 Schulen und 15 Firmen wurden angeschrieben bzw. angesprochen, ihnen das notwendige Informationsmaterial übermittelt und Gespräche angeboten. Dies bedurfte eines nicht zu unterschätzenden Zeitaufwandes und war selbstverständlich mit vielen Frustrationen verbunden. Letztendlich blieb aus verschiedenen Gründen das Markgrafen-Gymnasium in Karlsruhe-Durlach übrig. Sechs Auftraggeber konnten gewonnen werden (s.u.), so dass einem L2V-Start im Schuljahr 2015/16 nichts mehr im Wege stand.
Am 11./12. Mai 2015 wurde am TheoPrax-Zentrum in Pfinztal-Berghausen ein Qualifizierungs-Workshop für OJW- und Schulbetreuer der L2V Projekte abgehalten, den Frau Heidemann (DKJS) und Frau Jakob (TheoPrax) erfolgreich leiteten. Schwerpunkte waren die Themen Projektmanagement und Ziele und Vorgehensweise bei den L2V-Projekten.
Der Juni und Juli waren geprägt von der Themenfestlegung bei den Firmen und dem finden der Schülerteams, die sich dafür interessieren.
Die Themen für die Seminarkurse (Sk) bekam das Markgrafen-Gymnasium noch zum Ende des Schuljahres 14/15 und für die NwT Klassen 10 zu Beginn des Schuljahrs 15/16. Je drei Schülerteams der Jahrgangsstufe 1 (SK) und drei Schülerteams der NWT Klassen 10 wählten sich in die Themen ein.
Seminarkursthemen:
a. Greiferbahnhof: Gesucht sind Lösungen für die Lagerung der Werkzeuge (Roboter-Greifer), so dass der regelmäßige und gelegentliche Werkzeug-/Greiferwechsel bei den Tankblasmaschinen der Firma TI-automotive schnell und sicher durchgeführt werden kann. Die Lagerung muss so gestaltet werden, dass die vorhandenen und zukünftigen Greiferwerkzeuge sicher gelagert sind und ein automatischer Zugriff möglich ist.
b. Thermoelektrische Generatoren (TEG): Etliche TheoPrax-Projektarbeiten beschäftigten sich mit den Möglichkeiten und der Optimierung von TEG-Elementen. Hier geht es um die didaktische Fragestellung, wie kann das Wissen, die Anwendung und die Weiterentwicklung von TEGen Jugendlichen übermittelt werden.
c. Home-Hive Bienenkästen: Home-Hive Bienenkästen hat die Firma BieVital aus Holz teuer und arbeitsintensiv gebaut. Gesucht sind alternative Werkstoffe, die eine günstigere und billigere Bauweise ermöglichen und dabei noch bessere Bedingungen für die Bienenvölker und Witterungsschutz bieten.
NwT-Klassen 10- Themen:
a. 3D-Drucker: Für einen vorhandenen 3D-Drucker der OJW, soll ein didaktisches Konzept entwickelt werden, mit dessen Hilfe Jugendliche sich in die neue Technologie eigenständig einarbeiten und den vorhandenen 3D-Drucker sicher und sachgerecht benutzen können.
b. Gewächshaus: Die Schülerinnen und Schüler sollen auf ihre Berufswahl vorbereitet werden. Dazu sollen sie Techniken der elektronischen Steuerung an einem Gewächshaus-Modell erarbeiten und anwenden. Das Gewächshaus -Modell soll später als Anschauungs- und Informationsobjekt bei der Firma IBVS eingesetzt werden.
c. Kinetische Kunstobjekt: Die Firma Baumeister Schweißtechnik will für ihre Verkaufsräume oder im Außenbereich ein kinetisches Kunstwerk haben, das mit Licht und Schatten arbeitet und für die Kunden eine positive Anziehungskraft hat.
2. Schuljahr 2015/16 - Projektphase
Am 8.10.15 fand die Kick-Off-Veranstaltung für die Seminarkurse (Jahrgangsstufe 1) des Markgrafen Gymnasiums statt. Die Auftraggeber, die interessierten Schüler, Vertreter der OJW und von TheoPrax kamen zum ersten Mal zusammen, wurden über die allgemeinen Ziele und Bedingungen und den Verlauf der L2V-Projekte gemeinsam
detailliert informiert . Außerdem besprachen die Schülerteams zusammen mit den Auftraggebern genau die Ziele und Erwartungen, die hinter den Fragestellungen der Auftraggeber stehen.
Am 30.10.15 fand die Kick-Off-Veranstaltung für die drei Schülerteams der Klassenstufe 10 statt, die die L2V-Projekte im Rahmen des NwT-Unterrichts als Ersatz für eine Klassenarbeit bearbeiten. Der Ablauf und die Inhalte glichen dem Kick-Off der Seminarkurse.
Vom 18. bis 20.11.2015 wurden drei Workshops mit den Themen Kreativitätstechniken und Teambildung, organisiert von der DKJS, für die verschiedenen Projektgruppen umgesetzt.
Eine schwierige Phase war für die meisten Schüler die Ausarbeitung der Angebote. Hier zeigte sich deutlich, der Mangel an "Wirtschaftsbildung". Zeitpläne, Kostenaufstellungen, Ziel- und Ergebnisbeschreibungen, auch formale Dinge eines Geschäftsschreibens usw. bedurften intensiver Beratung und Hilfestellung.
3. Ausblick
Jetzt steuern die Projektgruppen auf die Zwischenpräsentation und den Zwischenbericht zu. Außerdem beginnt die heiße Phase der konkreten und praktischen Umsetzungen und Ausarbeitungen. Dabei wird es sicher auch nochmals Durststrecken geben - unter anderem beim Zeitmanagement und handwerklichen/technischen Umsetzungen, da hier zumindest von schulischer Seite keine Ausbildung vorliegt. Hier sind dann die OJW und die Betreuer der Firmen nochmals im besonderen Maß gefordert.
Schon jetzt lässt sich absehen, dass die Ergebnisse aller Gruppen den Anforderungen genügen und dabei ordentliche Ergebnisse erzielt und vielseitige Lernerfahrungen weit über jeden Schulunterricht hinaus gemacht werden.
4. Tabellarische Übersicht
|
|
|
L2V-Thema |
Auftraggeber (A) Betreuer (B) |
Dauer |
Tn- zahl |
|
1 |
Seminarkurs Markgrafen-Gymnasium |
Greiferbahnhof für eine Tankblas-Maschine |
Ulf Riehm (A/B) Firma: TI-automotive Hans Riehm (B) |
10/15 bis 7/16 |
3 |
|
2 |
Seminarkurs Markgrafen-Gymnasium |
Thermoelektrischer Generator - ein didaktisches Modell |
Peter Eyerer Firma: Ingenieurbüro Eyerer (A/B) |
10/15 bis 7/16 |
3 |
|
3 |
Seminarkurs Markgrafen-Gymnasium |
BieVital: Home-Hive Kästen aus Styrodur oder Bioschaum |
Marc La Fontaine - Firma: BieVital (A) Klaus Weber (B) |
10/15 bis 7/16 |
3 |
|
|
|
|
|
|
|
|
4 |
NwT Kl. 10 Markgrafen-Gymnasium |
3D-Drucker - eine Einführung für Jugendliche
|
Peter Eyerer (A) Firma: Ingenieurbüro Eyerer Andy Großmann (B) Stefan Essig (B) |
10/15 bis 6/16 |
2-3 |
|
5 |
NwT Kl. 10 Markgrafen-Gymnasium |
Bau eines Gewächshauses mit automatischer Steuerung |
Volkmar Spinnler Firma: IBVS Ingenieurbüro Spinnler (A/B) Hans Riehm (B) |
10/15 bis 6/16 |
4 |
|
6 |
NwT Kl. 10 Markgrafen-Gymnasium |
Kinetisches Kunstobjekt: Licht und Schatten |
Andreas Baumeister (A) Baumeister Schweißtechnik Hans Riehm (B) |
10/15 bis 6/16 |
3 |
|
|
|
|
|
|
|
Karlsbad, den 26.1.2016
Hans Riehm (OJW)
5. Anhang : Zeitungsscan vom 23.10.2015 Das Wochenmagazin:
Kick-off am Markgrafengymnasium
Schülerforschungszentrum Berchtesgadener Land (Bayern)
- Kickoff-Veranstaltung P-Seminar Gym. Berchtesgaden bei der Fa. psm protech GmbH & Co. KG
- Im Rahmen des Projekts fuhr das P-Seminar Physik des Gymnasiums Berchtesgaden zum Fraunhofer Institut nach Freising.
Zwischenpräsentation des ersten Lab2Venture-Projektes des Schülerforschungszentrums
Letzte Woche fand bei psm protech in Marktschellenberg die Zwischenpräsentation des ersten Lab2Venture Projektes des Schülerforschungszentrums Berchtesgadener Land statt. Im Rahmen des P-Seminars Physik erhielten die Schülerinnen und Schüler des Gymnasiums Berchtesgaden in Zusammenarbeit mit dem Schülerforschungszentrum Berchtesgadener Land von psm protech die Aufgabe, alternative Verwertungsmöglichkeiten für Kunststoff- und Hybridausschuss- und anfahrteile zu finden, diese zu präsentieren und eine Kosten-Nutzen-Rechnung in Bezug auf ein konkretes Bauteil zu erstellen.
In einer sehr anschaulichen Präsentation berichtete die Gruppe über das bisher Erreichte, von der Erstellung des Zeitstrukturplanes, der Materialanalyse bis zum Recherchieren von geeigneten Recyclingverfahren. Neben Kontakten zu klassischen Verwertungsfirmen, die mittels mechanischer Aufbereitung die Metallkomponenten zurückge
winnen können, konnte durch die Kontaktaufnahme mit dem Fraunhofer Institut für Verfahrenstechnik und Verpackung IVV in Freising, ein weiterer Meilenstein erreicht werden. In einem Pilotverfahren werden dort hybride Teile getrennt, so dass sowohl Metall- als auch Kunststoffkomponenten erhalten bleiben. Derzeit kümmert sich das Team um die Kosten für die unterschiedlichen Verfahren.
Foto Fa. psm protech, P-Seminar Physik des Gym. BGD mit Lehrer Günther Klauser, Lab2Venture Koordinatorin Petra Moderegger, Irene Wagner von der Fa. psm und zuständige Mitarbeiter
- Kathi und Thomas bei der Firma psm protech mit Firmeninhaberin Irene Wagner und Projektleiterin Kerstin Thiel, um sich weitere Informationen zu den Hybridteilen zu beschaffen
Zeitgleich startet auch unser nächstes Lab2Venture-Projekt ins Zusammenarbeit mit der Mädchenrealschule Sparz und der Fa. Hawle Armaturen GmbH.
Vom Ausbildungsleiter H. Bauer und den Azubis erhielten wir eine interessante Betriebsführung und die ersten Details für das Projekt konnten schon besprochen werden.
.jpg)


Für die Schülerinnen und Schüler des P-Seminars Physik des Gym. Berchtesgaden wurde im Rahmen ihres Lab2Ventures ein Workshop zur Vorbereitung auf die Abschlusspräsentation angeboten. Die Teilnehmerinnen und Teilnehmer konnten viele Tipps für ihre in Kürze stattfindende Abschlusspräsentation mitnehmen.


Auch die Lehrkräfte der Maria-Ward-Realschule in Bad Reichenhall nutzten die Gelegenheit zur Teilnahme an einem Workshop zum Thema "Projektmanagement"



Die Schülerinnen der RS Sparz in Traunstein starteten ihr Lab2Venture-Projekt mit einem Workshop zum Thema "Angebotserstellung"



Im Rahmen der Projektpräsentation unserer Partnerschule, der RS Rupertiwinkel in Freilassing, konnten wir drei kleinere Lab2Venture-Projekte abwickeln. Eines davon war die Erstellung eines Imagefilms für das Sägewerk Saghäusl in Berchtesgaden.
Die Fotos zeigen den Geschäftsführer Christoph Geistlinger bei der Begrüssung, die Ehrengäste, die Schüler bei der Präsentation und die gesamte Gruppe mit Schulleiter Dieter Thoma, Projektbetreuer Franz Stempfer, Geschäftsführer Christoph Geistlinger vom Schülerforschugnszentrum u. die Lab2Venture Beauftragte Petra Moderegger.
Glänzender Abschluss des P-Seminars des Gymnasiums Berchtesgaden mit psm protech im Rahmen eines Lab2Venture-Projekts
10 Schüler beeindruckten mit ihrer Abschlusspräsentation über die von psm protech gestellte Aufgabe „Alternative Verwertungsmöglichkeiten für hybrides Ausschussmaterial zu finden“.
Ziel der gestellten Aufgabe war es, nach dem Stand der Technik, alternative Verwertungswege für hybrides Ausschussmaterial (Metall-Kunststoff-Verbundteile), auch in einem Verwertungsverbund mit anderen Firmen, aufzuzeigen und zu bewerten. Die Gruppe startete mit einer intensiven Schulung zum Thema Projektmanagement, die von Frau Bettina Oestreich, die mit ihrer Erfahrung in diesem Bereich, das Schülerforschungszentrum unterstützt, durchgeführt wurde. Die engagierten Schüler mit ihrem Lehrer, Herrn Günther Klauser, bearbeiteten mit Unterstützung der Projektleiterin von psm protech, Kerstin Thiel, in verschiedenen Projektgruppen die gestellten Aufgaben. Dazu wurden in der Gruppe, die sich als „Green Recycling Projekt“ bezeichnete und auch ein eigenes Logo hierfür entwickelte, Verantwortlichkeiten festgelegt: Als Teamleiter fungierte Lukas Brandner, die Kommunikationsleitung und Schnittstelle zu externen Firmen übernahm Katharina Renoth. Thomas Moderegger war für Controlling und Protokollführ
ung zuständig, Patrick Vietze übernahm die Aufgabe des Diskussionsleiters und Cevin Wechslinger stellte die Schlussrechnung.
Kontakte zu verschiedenen Firmen, auch überregional wurden hergestellt. Als wichtiger Kontakt stellte sich hier Herr Dr. Martin Schlummer vom Fraunhofer Institut in Freising dar, der bereits erste Forschungsergebnisse in alternativen Verwertungsmethoden aufzeigen konnte und Ausschussmaterial von psm protech mittestete.
Letzte Woche war es dann soweit – mit ihrer Abschlusspräsentation überzeugten die Schüler die Geschäftsleitung und Projektleitung von psm protech, die Schulleitung Herrn Schöberl und Herrn Spiegel-Schmidt, die Projektkoordinatorin vom Schülerforschungszentrum Berchtesgadener Land, Frau Moderegger und alle weiteren Zuhörer.
Irene Wagner und Kerstin Thiel bedankten sich für die engagierte Arbeit und den gelungenen Vortrag mit einem Geschenk und betonten, auf den Ergebnissen weiter aufbauen zu wollen.
Der Schulleiter des Gymnasiums Berchtesgaden, Herr Schöberl, ergänzte, dass er derartige Projektseminare zukünftig weiter unterstützen möchte.
Als Resümee aller Teilnehmer wurde festgestellt, dass P-Seminare in Zusammenarbeit mit Wirtschaftsunternehmen und dem Schülerforschungszentrum die Schüler auf das Berufsleben vorbereiten und ihnen erste Eindrücke in die Arbeitswelt vermitteln.
Die Projekte mit der RS Rupertiwinkel sind abgeschlossen. Letzte Woche erfolgte die Überreichung der Zertifikate an die Schüler. Im Rahmen der Zertifikatsübergabe kamen aus den Reihen der Schüler viele gute Anregungen für die Projekte im nächsten Jahr.
Auf dem Foto die Klasse 9 a der Rupertiwinkel RS in Freilassing mit dem betreuenden Lehrer Franz Stempfer und Petra Moderegger vom Schülerforschungszentrum.
Letzte Woche fand in der Realschule Sparz ein Projekttag im Rahmen des Lab2-Venture Projekts statt. Die Schülerinnen sind bei der Erstellung der Flucht- und Rettungspläne schon sehr gut vorangekommen.



Wir gratulieren dem P-Seminar "Life Cycle Management" des Gymnasiums Berchtesgaden zum P-Seminar-Preis des Verbandes der bayerischen Wirtschaft.
Das Seminar wurde als eines von 24 P-Seminaren aus ganz Bayern und als eines von drei aus Oberbayern-Ost als Gewinner der ersten Runde ausgewählt. Der Preis wurde vom MB Oberbayern-Ost, Richard Rühl, übergeben.
Die P-Seminar-Gruppe mit MB Rühl bei der Preisübergabe
alle ausserschulisch Beteiligten des Projekts
bei der Präsentation
Die erfolgreiche Gruppe nach der Preisverleihung!
In einer kleinen Feierstunde wurde den Schülerinnen und Schülern des P-Seminars ihre Zertikate durch Petra Moderegger, Lab2Venture Beauftragte des Schülerforschungszentrums, überreicht.
Am 08.03. fand das Kickoff für das Lab2Venture-Projekt in der RS St. Zeno in Bad Reichenhall statt. Nachdem die Schülerinnen viele Informationen zum geplanten Projekt erhielten, fand noch der Präsentations-Workshop für die Schülerinnen statt. Die Schülerinnen werden in ihrem Projekt Modelle für die Gestaltung einer Freifläche des Pausenhofs bauen.


Das Projekt mit der RS Sparz und der Fa. Hawle ist nun abgeschlossen. Die Zertifikate wurden an die Schülerinnen überreicht.
Die Mädchen der Klasse 9a entwarfen im Rahmen des Auftrags/Projekts verschiedene Flucht- und Rettungswegepläne einzelner Abteilungen der Firma Hawle Armaturen GmbH. Die Grundlagen hierfür hatten die Schülerinnen bereits von ihren Lehrkräften im CAD- und Informatik-Unterricht erlernt und konnten ihre Kenntnisse nun in der Praxis anwenden. So wurde das Potential, das die jungen Damen mitbrachten, für die Wirtschaft und die Wissenschaft nutzbar gemacht. Hieraus ergab sich eine „Win-Win-Situation“ für alle Beteiligten:
Zum einen für die Firma Hawle Armaturen GmbH, welche die erstellten Flucht- und Rettungswegepläne direkt zum Einsatz bringen konnte und darüber hinaus noch von den Flyern zum Thema Sicherheit und Brandschutz in englischer Sprache profitierte. Zum anderen erlebten die Schülerinnen die Realität im Arbeitsleben, vertieften selbstständiges, eigenverantwortliches und problemorientiertes Arbeiten in Gruppen zusammen mit den Auszubildenden der Firma Hawle Armaturen GmbH, bekamen einen Einblick in verschiedene Berufsfelder und lernten ihre Stärken und Schwächen genauer kennen. Des Weiteren konnte die ausführliche Evaluation des Projekts einen Beitrag zur empirischen Bildungsforschung leisten.
Im Rahmen der Abschlusspräsentation im Schülerforschungszentrum Berchtesgadener Land zeigte sich Hubert Bauer besonders erfreut über die einfallsreichen Vorschläge zur Umsetzung verschiedener Orientierungshilfen zum Thema Sicherheit und Brandschutz im Produktionsbereich des Unternehmens. Katja Dumberger hob den Mehrwert für die Firma Hawle Armaturen GmbH hervor, die davon profitierte, kreative Lösungen für Fragestellungen aus dem Blickwinkel der Sparzer Schülerinnen erhalten zu haben. Besonders beeindruckt zeigten sich die Auszubildenden der Firma Hawle Armaturen GmbH über die Präsentationen der jungen Schülerinnen, die überwiegend in englischer Sprache abgehalten wurden. Maria Galamb und Elisabeth Widmann, die das Projekt begleiteten, waren begeistert von dem modernen Unternehmen. Darüber hinaus konnten sie sich neues Fachwissen aneignen und ihre Kompetenzen im Rahmen von Fortbildungen erweitern. Zudem ergab sich ein enger Kontakt zur Maria-Ward-Mädchenrealschule Traunstein- Sparz bzw. zu eventuellen Auszubildenden, zur Technischen Universität München und zum Schülerforschungszentrum Berchtesgadener Land.


Die 9. Klasse der Maria-Ward-Realschule in Bad Reichenhall besuchte gestern zu ihrem ersten Projekttag die Werkstatt des Schülerforschungszentrums Berchtesgadener Land. Die Architektin Alexandra Scholz-Kirchleitner und Monika Gasteiger, die Leiterin der Werkstatt, unterstützten die Schülerinnen bei der Umsetzung ihrer Ideen zur Gestaltung der Freifläche im Außenbereich der Schule.
Eindrücke vom 2. Projekttag der Maria-Ward-Realschule in der Werkstatt des Schülerforschungszentrums. Geschäftsführer Christoph Geistlinger informierte sich bei den Schülerinnen über den Stand ihres Projekts.


Am 3. Projekttag gingen die Schülerinnen bei ihren Modellen schon ins Detail. Die praktische Arbeit macht den Schülerinnen sichtlich Spaß.
Am 17.06. fand nun die Abschlusspräsentation für unser Lab2Venture-Projekt mit der Maria-Ward-Realschule aus Bad Reichenhall statt.
Die Schülerinnen waren schon lange vor Beginn der Veranstaltung im Schülerforschungszentrum, um ihre Präsentationen noch einmal zu proben und Fotos von ihren Modellen zu machen. Die Aufregung war grenzenlos, aber nach erfolgter Begrüssung durch die Geschäftsführung des Schülerforschungszentrums und Elke Becker, die extra aus Karlsruhe angereist war, gingen alle konzentriert an die Präsentation. Die Schulleiterin und die anwesenden Lehrkräfte waren begeistert von den Ideen der Mädchen und versprachen, möglichst viele der Ideen umzusetzen. Geplant ist von der Schulleitung, dass die Mädchen ihre Modelle auch noch vor den Zuständigen des Ordinariats präsentieren.
Schülerforschungszentrum Berlin (Berlin)
Das Projekt wird vorbereitet - der Lab2Venture Qualifizierungsworkshop
Am 24. und 25.6.2015 fanden in Berlin die Lab2Venture-Qualifizierungsworkshops statt. Wie können Schulen, Schülerlabore und Unternehmen so zusammenarbeiten, dass innovative Ideen umgesetzt werden? Welches Know-how brauchen die Pädagogen der Schülerlabore für die Umsetzung von Projekten mit der Wirtschaft? Wie lässt sich ein Projekt sowohl mit dem Rahmenlehrplan als auch mit dem Schulstundenplan vereinbaren? Diese Fragen diskutierten die Vertreter vom Schülerlabor NatLab der FU Berlin und vom Schülerforschungszentrum Berlin an der Lise-Meitner-Schule mit Lehrkräften von 7 verschiedenen Berliner Schulen.
Viele ganz praktische Aspekte standen im Mittelpunkt des Qualifizierungsworkshops von Lab2Venture in Berlin. Neben Einführungen zu Kreativitätstechniken, Projektmanagement und der Förderung von Entrepreneurial Skills tauschten sich die Teilnehmenden auch aus über rechtliche Fragen der Projektumsetzung, über Wirtschaftlichkeit, geeignete Räumlichkeiten oder den erforderlichen Betreuungsaufwand für die Lehrkräfte.
Das Projekt beginnt - der Lab2Venture Kick-off Veranstaltung
Am 7.10.15 ging es für das Schülerforschungszentrum Berlin mit der feierlichen Kick-off Veranstaltung mit dem Projekt Lab2Venture los. Das Schülerforschungszentrum Berlin an der Lise-Meitner-Schule fungiert bei Lab2Venture als Bindeglied zwischen Schule auf der einen Seite und Unternehmen sowie Wissenschaft auf der anderen Seite. Mit dem Arndt-Gymnasium, der Wolfgang-Borchert-Schule, der Grünauer Schule und der Lise-Meitner-Schule konnten insgesamt vier Schulen aus ganz Berlin durch das SFZ Berlin für eine Kooperation gewonnen werden. Als Auftraggeber fungieren die Technische Universität Berlin, das Leibniz-Institut für Kristallzüchtung sowie der 3D Printshop Berlin.
Bei der feierlichen Startveranstaltung am 7.10 trafen sich die rund 70 teilnehmenden Schülerinnen und Schüler mit den Auftraggebern und den Projektpartnern.
Die Projekte werden an den Schulen und im SFZ Berlin durchgeführt
Ende 2015 sowie anfang 2016 gingen die Aufträge der Unternehmen und Institute an die Schülerinnen und Schüler raus. Inzwischen liegen sogar die ersten spannenden Ergebnisse vor.
Abschlussveranstaltung am 18.7.2016
Am 18.7. planen wir eine große Lab2Venture Abschlussveranstaltung in der Räumlichkeiten des Bundesministeriums für Wirtschaft und Energie. Wir sind sehr gespannt auf die Präsentationen der einzelnen Projektgruppen und drücken allen Beteiligten die Daumen für die letzte Phase der Aufrträge.
Schülerlabor des Botanischen Gartens der Philipps Universität Marburg (Hessen)
Kurzbericht
 |
 |
|
Am Montag, den 12. Oktober 2015 fiel der Startschuss für das Lab2venture Projekt im Schülerlabor des Botanischen Gartens der Philipps Universität Marburg. Das Schülerlabor nimmt in den kommenden zwei Jahren als eines von zwölf deutschlandweit ausgewählten Schülerlaboren am Projekt „Lab2Venture“ teil. Das vom Bundesministerium für Wissenschaft und Technologie geförderte Projekt ermöglicht Jugendlichen, zu echten naturwissenschaftlichen Problemstellungen von Unternehmen und der Universität selbständig zu experimentieren und zu forschen. Getragen wird das Projekt vom TheoPrax-Zentrum im Fraunhofer Institut für Chemische Technologie, der Deutschen Kinder- und Jugendstiftung sowie von LernortLabor, dem Bundesverband der Schülerlabore.
Im Rahmen des Projekts werden in den nächsten Monaten Schülerinnen und Schüler aus der Herderschule Gießen, der Freien Waldorfschule Marburg und dem Landschulheim Steinmühle an echten Fragestellungen aus der Wissenschaft arbeiten. Drei Professoren der Universität Marburg und die Firma Schneider Optik aus Fronhausen haben dazu konkrete Forschungsfragen für die Schülergruppen bereitgestellt. Für die Genetiker um Herrn Professor Bölker werden die Schüler genetische Merkmale des Maisbeulenbrands, ein Pilz der Maispflanzen befällt analysieren. Frau Professor Hassel aus der Speziellen Zoologie benötigt für die Mikroskopie von Süsswasserpolypen ein schonendes Verfahren zur Fixierung der Tiere und bei der Entwicklungsbiologin Frau Professor Önel wird ein genetisches Screening an Fruchtfliegen durchgeführt, um bestimmte Geninteraktionen zu untersuchen. Die Fragestellung der Firma Schneider Optik ist hingegen eher im physikalischen Bereich angesiedelt, die Schülerinnen und Schüler werden sich im Rahmen ihrer Arbeit mit der Oberflächenbehandlung von optischen Linsen beschäftigen.
Die Auftraggeber stellen für die Bearbeitung der Fragestellungen jeweils ein kleines Budget zur Verfügung. Die Schülerteams lernen dabei also nicht nur, fachliche Fragen zu bearbeiten, sondern auch unternehmerisches Denken. Das neue Projekt bietet somit mehr als ein Kurs im Schülerlabor“, sagt Malte Klimczak, abgeordneter Lehrer des Schülerlabors der Philipps-Universität. „In der Zusammenarbeit mit Unternehmen befassen sich die Jugendlichen mit anwendungsnahen Themen und lernen so auch, wie Wirtschaft funktioniert.“ Die Schülerinnen und Schüler erhalten durch das Fraunhofer Institut und die DKJS zudem begleitende workshops, die sie für ihre Arbeit im Team qualifizieren.
Betreut werden die Schüler von ihren Lehren Frau Wagner (Herderschule Gießen), Frau Seel (Freie Waldorfschule) und Frau Töhl-Borsdorf (Landschulheim Steinmühle), von den beiden studentischen Hilfskräften Franziska Helmsen und Matthias Möller sowie sowie den Mitarbeitern des Schülerlabors des Botanischen Gartens Malte Klimczak und Christian Deurer.
Das Schülerlabor erhält für die Durchführung des Projekts eine finanzielle Unterstützung durch das Bundesministerium für Wissenschaft und Technologie. Zusätzliche finanzielle Mittel stellt der Sonderforschungsbereich 987 der DFG zur Verfügung. Der Sprecher des SFB 987, der Mikrobiologie Herr Professor Bremer, freut sich in diesem Zusammenhang den naturwissenschaftlichen Nachwuchs zu fördern und einen Einblick in die aktuelle Forschung zu geben.
Projekte
Projekt 1: Entwicklung eines Verfahrens zur Fixierung des Süsswasserpolypen Hydra vulgaris für die Mikroskopie
Im Rahmen des Projektauftrags sollen die Schüler eine Flüssigkeitskammer bauen, in der der lebende Polyp für die Mikroskopie lebend fixiert und immobilisiert werden kann. Auftraggeber: Philipps Universität Marburg, Frau Prof. Hassel. Teilnehmer: René Ruhs; Nils Andre Schäfer; Tim Luca Eggers; Till Christian Nijenhuis (Herderschule Gießen)
Projekt 2: Durchführung eines Modifier-Screen des Gens „kette“ bei Drosophila melanogaster
Im Rahmen des Projektauftrags sollen die Schüler einen sogenannten Modifier-Screen eines Gens namens „kette“, welches bei der Augenentwicklung von Drosophila eine Rolle spielt, durchführen. Dazu werden zunächst wildtypische Augen unter dem Binokular mit Augen von Tieren verglichen die das Gen „kette“ in ihren Photorezeptoren exprimieren. Hier sollte man einen rauen Augenphänotyp beobachten. Anschließend werden verschiedene Mutanten mit Tieren, die das Gen „kette“ tragen gekreuzt und es wird untersucht, ob diese Mutationen den Augenphänotyp abschwächen oder verstärken. Auf diese Weise werden genetische Interaktionspartner des Gens „kette“ identifiziert. Auftraggeber: Philipps Universität Marburg, Frau Prof. Önel. Teilnehmer: Inga Interwies, Sophie Dönges, Anne Mack, Fiona Caroline Metsch, Katrin Hannah Stöhr, Tobias Maximilian Post (Herderschule Gießen)
Projekt 3: Genetische Typisierung von Maisbeulenbrand
Im Rahmen des Projektauftrags sollen die Schüler die genetische Konfiguration der lokalen Maisbeulenbrandpopulation untersuchen. Dazu müssen infizierte Maispflanzen im Umland von Marburg gesammelt werden, um dann mithilfe von molekularbiologischen Methoden die genetische Konfiguration zu ermitteln. Auftraggeber: Philipps Universität Marburg, Herr Prof. Bölker. Teilnehmer: Lena Burger, Joana Jacqueline Menzel, Laurens Roolfs (Herderschule Gießen, Waldorfschule Marburg)
Projekt 4: Entwicklung einer Apparatur zur Ermittlung von Abzugskräften von Schutzfolien für optische Linsen
Im Rahmen des Projekts soll eine Apparatur zur Ermittlung von Abzugskräften von gängigen Schutzfolien zum Blocken entwickelt werden, die Transparenz im aufgeklebten Zustand ermittelt werden sowie eine Bewertung über die Kleber-Rückstände nach Entfernung der Folie erfolgen. Auftraggeber: Schneider Optik Fronhausen, Frau Dr. Stry. Teilnehmer: Riko Uphoff, Lia Essers, Tomas Heinrich, Fabian Grigat, Johanna Sodmann, Philllip Pausch (Landschulheim Steinmühle Marburg)
Chronologie
|
|
 |
 |
26.05.2015 & 27.05.2015
Lab2venture Fortbildung durch TheoPrax und DKJS für die Mitarbeiter des Schülerlabors und interessierte Lehrkräfte (12 Teilnehmer)
12.10.2015
Kick-Off Treffen mit teilnehmenden Schülerinnen und Schülern, Lehrern und Auftraggebern. Insgesamt haben sich vier Arbeitsteams gefunden. Drei Teams an der Herderschule Gießen/Waldorfschule Marburg und ein Arbeitsteam am Landschulheim Steinmühle in Marburg.
20.11.2015
Workshop für teilnehmende Schülerinnen und Schüler zum Thema Projektmanagement nach der TheoPrax Methode und Teambuilding durch Theoprax und DKJS
16.02.2016 und 18.03.2016
Zwischenpräsentation der Arbeitsergebnisse durch die Arbeitsteams für die Auftraggeber
solaris, Chemnitz (Sachsen)
Schwerpunkte der Arbeit im Projekt Lab2Venture in 2015 waren das Finden der schulischen und unternehmerischen Partner, die Akquisition der Schülerinnen und Schüler, ein Qualifizierungs-Workshop für interessierte Lehrerinnen und Lehrer, die Kick off Veranstaltung zum eigentlichen Start der Schülerprojekte sowie der Beginn der Arbeiten zur der Lösung der Aufgabenstellungen.
Im April 2015 wurde ein zweitägiger Qualifizierungs-Workshop „Wegweiser Unternehmerisches Denken und Handeln“ durchgeführt. Eingeladen waren Lehrerinnen und Lehrer von Chemnitzer Gymnasien und Oberschulen, Mitarbeiterinnen und Mitarbeiter von Schülerlaboren sowie Unternehmerinnen und Unternehmer. Ziele waren u. a. Fragen unternehmerischen Denkens und Handelns mit Schulprojekten zu verknüpfen, Kooperationen mit Privatunternehmen und öffentlichen Arbeitgebern entlang von realen Auftragsverhältnissen zu diskutieren und im Anschluss weiterführende Angebote zu realisieren. Teilgenommen haben dreizehn Vertreterinnen und Vertreter von zwei Gymnasien, fünf Oberschulen und einer Förderschule. Durchgeführt wurde der Workshop durch Theoprax, die Deutsche Kinder- und Jugendstiftung und LernortLabor – Bundesverband der Schülerlabore. Inhaltlich wurden das Projektmanagement, Methoden zur Ideenfindung, die Firmenakquise und die Projektarbeit mit den Jugendlichen besprochen. Die Teilnehmenden fanden sich durch diese Veranstaltung gut informiert und motiviert, in ihren Einrichtungen entsprechende Projekte zu fördern und zu unterstützen. Durch die Sächsische Bildungsagentur wurde der Workshop für die Lehrerinnen und Lehrer als Weiterbildung anerkannt.
Die Gewinnung von Schülerinnen und Schüler für die Bearbeitung von Projektthemen gestaltete sich auf Grund der engen Zusammenarbeit und der Kooperation mit den Chemnitzer Oberschulen und Gymnasien in den letzten Jahren problemlos. Für drei geplante Themen konnten Projektteams gewonnen werden.
Im November 2015 fand das Kick off-Treffen für diese drei Schülerthemen statt. Ziel der Veranstaltung war es, alle Beteiligten, also Auftraggeber, Schülerinnen und Schüler sowie Betreuer in Austausch zu bringen, einander kennen zu lernen und wichtige Fragen zu den Themen zu klären. Folgende Projektthemen werden nun bis zum Ende des Schuljahres 2015/2016 angegangen:
„Eine Sonne für den Tierpark“
Der Auftrag durch die Tierparkschule bzw. den Amerika-Tierpark in Limbach-Oberfrohna wird durch drei Jugendliche aus der Oberschule Schönau-Siegmar bzw. der AG Elektronik-Informatik bearbeitet. Ziel ist die Entwicklung einer Anschauungstafel zum Thema Sonne. Eine Elektronik zeigt dabei optisch durch mehrere LED die Stärke der Sonneneinstrahlung an und ein Text erläutert die Bedeutung der Sonne für Mensch, Tier und Pflanzen.
„Schülerfutter“
Ziel des Projektes soll es sein, eine App zu entwickeln, die aufzeigt welche Unternehmen Jobs und Praktika anbieten und gleichzeitig Schüler und Studenten erfassen, die auf der Suche danach sind. Es soll eine unkomplizierte und besonders schnelle Form der Kontaktaufnahme untereinander ermöglicht werden. Auftraggeber ist hierbei die PES-Projekt & Eventschmiede in Chemnitz. Bearbeitet wird das Thema durch drei Jugendliche der OS Schönau-Siegmar.
„Fliegen wie Baumgarten“
Dieses Thema ist eine Weiterführung des Projektes „Georg Baumgarten - Der fliegende Oberförster aus Grüna“ aus dem letzten Schuljahr. Die Recherche und der Aufbau eines Flugmodelles nach Entwürfen des sächsischen Luftschiffpioniers Georg Baumgarten ist das Projektthema für den Grünaer Heimatverein. Drei Jugendliche der Oberschule Am Flughafen bearbeiten diese Aufgabe. Diese Aufgabe soll den Neuaufbau der Baumgartenausstellung im Heimatverein Grüna bereichern.
teutolab-biotechnologie, Bielefeld (NRW)
Das teutolab-biotechnologie ist ein Mitmach- und Experimentierlabor. Es wurde 2010 gegründet und bietet verschiedene Angebote (Lehrerfortbildungen, Experimentierkurse, Projektarbeit, Projektkurse, Ferienkurse…) zum Erlernen und Erfahren von biotechnologischen Arbeitsweisen sowie deren Relevanz im alltäglichen Leben.
Nach erfolgreicher Teilnahme am Lab2Venture Projekt im Jahr 2013 wurde das Labor auch in diesem Projektfortführung (Lab2Venture Plus) als teilnehmendes Labor ausgewählt.

September 2015
Bei der Kickoff-Veranstaltung im Center for Biotechnology (CeBiTec) in Bielefeld informierten die „Auftraggeber“ die drei Schülergruppen und die Vertreter der jeweiligen Schulen über die im Rahmen des Lab2Venture-Projektes zu bearbeitenden Forschungsprojekte.
Die Schüler hatten die Gelegenheit, Fragen zu den vorgestellten Projekten zu stellen.
Oktober/November 2015
Nach Einführung in die Grundlagen des Projektmanagements, lernten die Schüler lernten anhand praktischer Übungen, konkrete Projektziele zu formulieren und die zum Erreichen dieser Ziele notwendigen Schritte in einen Projektzeitplan darzustellen.
Auf der Grundlage dieser Kenntnisse vertieften die vier Schülergruppen ihre Überlegungen zur Umsetzung des jeweiligen Projektes und verfassten ein Angebot an den Auftraggeber.
Ab Dezember 2015
In den folgenden Monaten können die Schülergruppen das Schülerlabor teutolab-biotechnologie nutzen, um unter wissenschaftlicher Begleitung ihre jeweiligen Projekte zu bearbeiten.
Projekt: Biologische Reiniger
Eine Partnerfirma entwickelt biologische Reiniger (z.B. für die Entfernung von Fetten). Diese Reiniger beinhalten z.B. Mikroorganismen, die Fette abbauen können.
Gelegentlich bilden sich in diesen Reinigern Fremdverkeimungen.
Das Ziel des Lab2Venture-Projektes ist es, diese Fremdverkeimungen (Bakterien, Algen, Pilze) zu untersuchen und ggf. eine Empfehlung an den Auftraggeber zu geben, wie diese Fremdverkeimungen verhindert werden können.
- Mikroskopieren der Keime
- Kultivierung der Keime auf Nährmedien
- Identifizierung der Keime (z.B. mikrobiologische, gentechnische Tests)
- Eigenschaften der Keime (Unter welchen Bedingungen wächst nur der gewünschte Keim, aber keine Fremdkeine?)
Projekt: ligninverwertende Bakterien
Ein Lebensmittellabor interessiert sich für Lignin-abbauende Bakterien. Lignin ist ein hochkomplexes Polymer und Bestandteil der Zellwand (insbesondere bei verholzten Pflanzen). Es ist eines der häufigsten Biopolymere in der Biosphäre, hat allerdings als Nährstoffsubstrat/chemisches Substrat eine untergeordnete Rolle, da der Aufschluss von Lignin aufwendig ist und nur sehr wenige Organismen bekannt sind, die Lignin abbauen können. Im Darm von Organismen, die vermutlich lignifizierte Pflanzen fressen, leben solche Organismen.
Das Ziel des Lab2Venture-Projektes ist es, eine Genomanalyse von Darmbewohnern eines pflanzenverwertenden Organismus durchzuführen, um so ligninverwertende Bakterien zu identifizieren.
- Präparation und DNA-Isolierung aus Darmmaterial
- Vervielfältigung und Klonierung eines geeigneten DNA-Abschnittes
- Sequenzierung und Identifizierung (durch Datenbankabgleich) der Darmorganismen
- Eigenschaften der Organismen (Welche können Lignin abbauen?)
Projekt: Zusammensetzung Biofilme
Einer der Auftraggeber beschäftigt sich mit dem Thema Biodilme. Biofilme sind Schleimschichten, die sich an Grenzflächen (fest/flüssig) bilden und in die verschiedene Mikroorganismen, zum Teil humanpathogene Mikroorganismen, eingebettet sind. Insbesondere sind Biofilme in Leitungs- und Trinkwasserinstallationen oder auch in Kathedern unerwünscht. Bei der Bildung von Biofilmen werden verschiedene Stadien durchlaufen; auch die Zusammensetzung der Organismen unterscheidet sich in den Stadien.
Ziel des Lab2Venture-Projektes ist es, die Organismen-Zusammensetzung unterschiedlicher Stadien eines Biofilmes zu analysieren.
- Isolierung der DNA aus Biofilmproben unterschiedlicher Stadien
- Vervielfältigung und Klonierung eines geeigneten DNA-Abschnittes
- Sequenzierung und Identifizierung (durch Datenbankabgleich) der Organismen
- Eigenschaften der Organismen (Welche Organismen bilden sich wann in einem Biofilm? Wie kann das vermieden werden?)



















